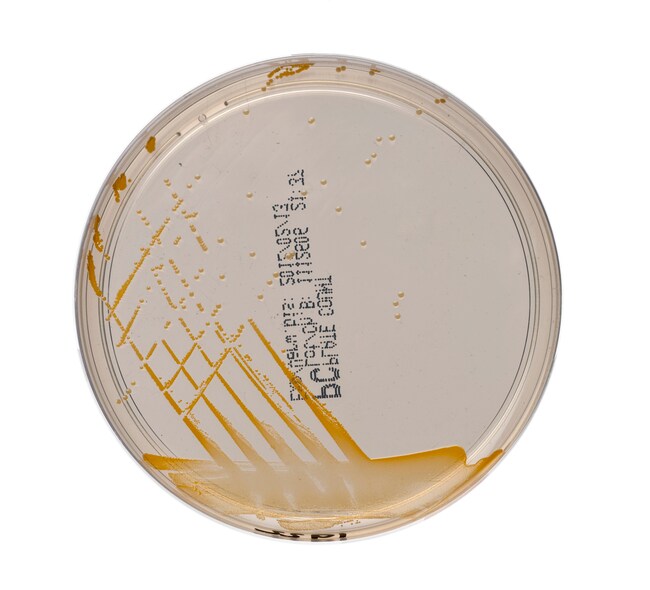
Plate Count Agar

Search
Thermo Scientific™
Plate Count Agar
Enumerate viable organisms in milk, water, food and dairy products using this non-selective medium.
| 货号 | 数量 | 产品规格 | 培养基类型 | 原料来源 |
|---|---|---|---|---|
| PO0158A | 10/Pk. | 90mm Monoplate | Plate Count Agar | 英国 |
货号 PO0158A
价格(CNY)
-
数量:
10/Pk.
产品规格:
90mm Monoplate
培养基类型:
Plate Count Agar
原料来源:
英国
Enumerate viable organisms in milk, dairy products, water, food and other specimens of sanitary importance using non-selective Thermo Scientific™ Plate Count Agar.
This standard medium meets the formulation of APHA, AOAC and PHLS.
Not all products are available for sale in all territories. Please inquire.
Remel™ and Oxoid™ products are now part of the Thermo Scientific brand, combining powerful manual, semi-automated and fully automated test products and a comprehensive line of media and diagnostic products to offer a complete, end-to-end solution to quickly deliver the products you need and the quality results your laboratory depends on.
Not all products are available for sale in all territories. Please inquire.
Remel™ and Oxoid™ products are now part of the Thermo Scientific brand, combining powerful manual, semi-automated and fully automated test products and a comprehensive line of media and diagnostic products to offer a complete, end-to-end solution to quickly deliver the products you need and the quality results your laboratory depends on.
供实验室使用
供实验室使用
规格
认证/合规Tested in accordance with CEN ISO/TS 11133-2.
颜色透明秸秆
容纳重量19.5g ± 1.0g
产品规格90mm Monoplate
培养基类型Plate Count Agar
包装类型Flow Wrapped - Single Layer
数量10/Pk.
有效期14 Weeks
原料来源英国
产品类型Agar Plate
Unit SizeEach
内容与储存
2° to 10°C, away from light